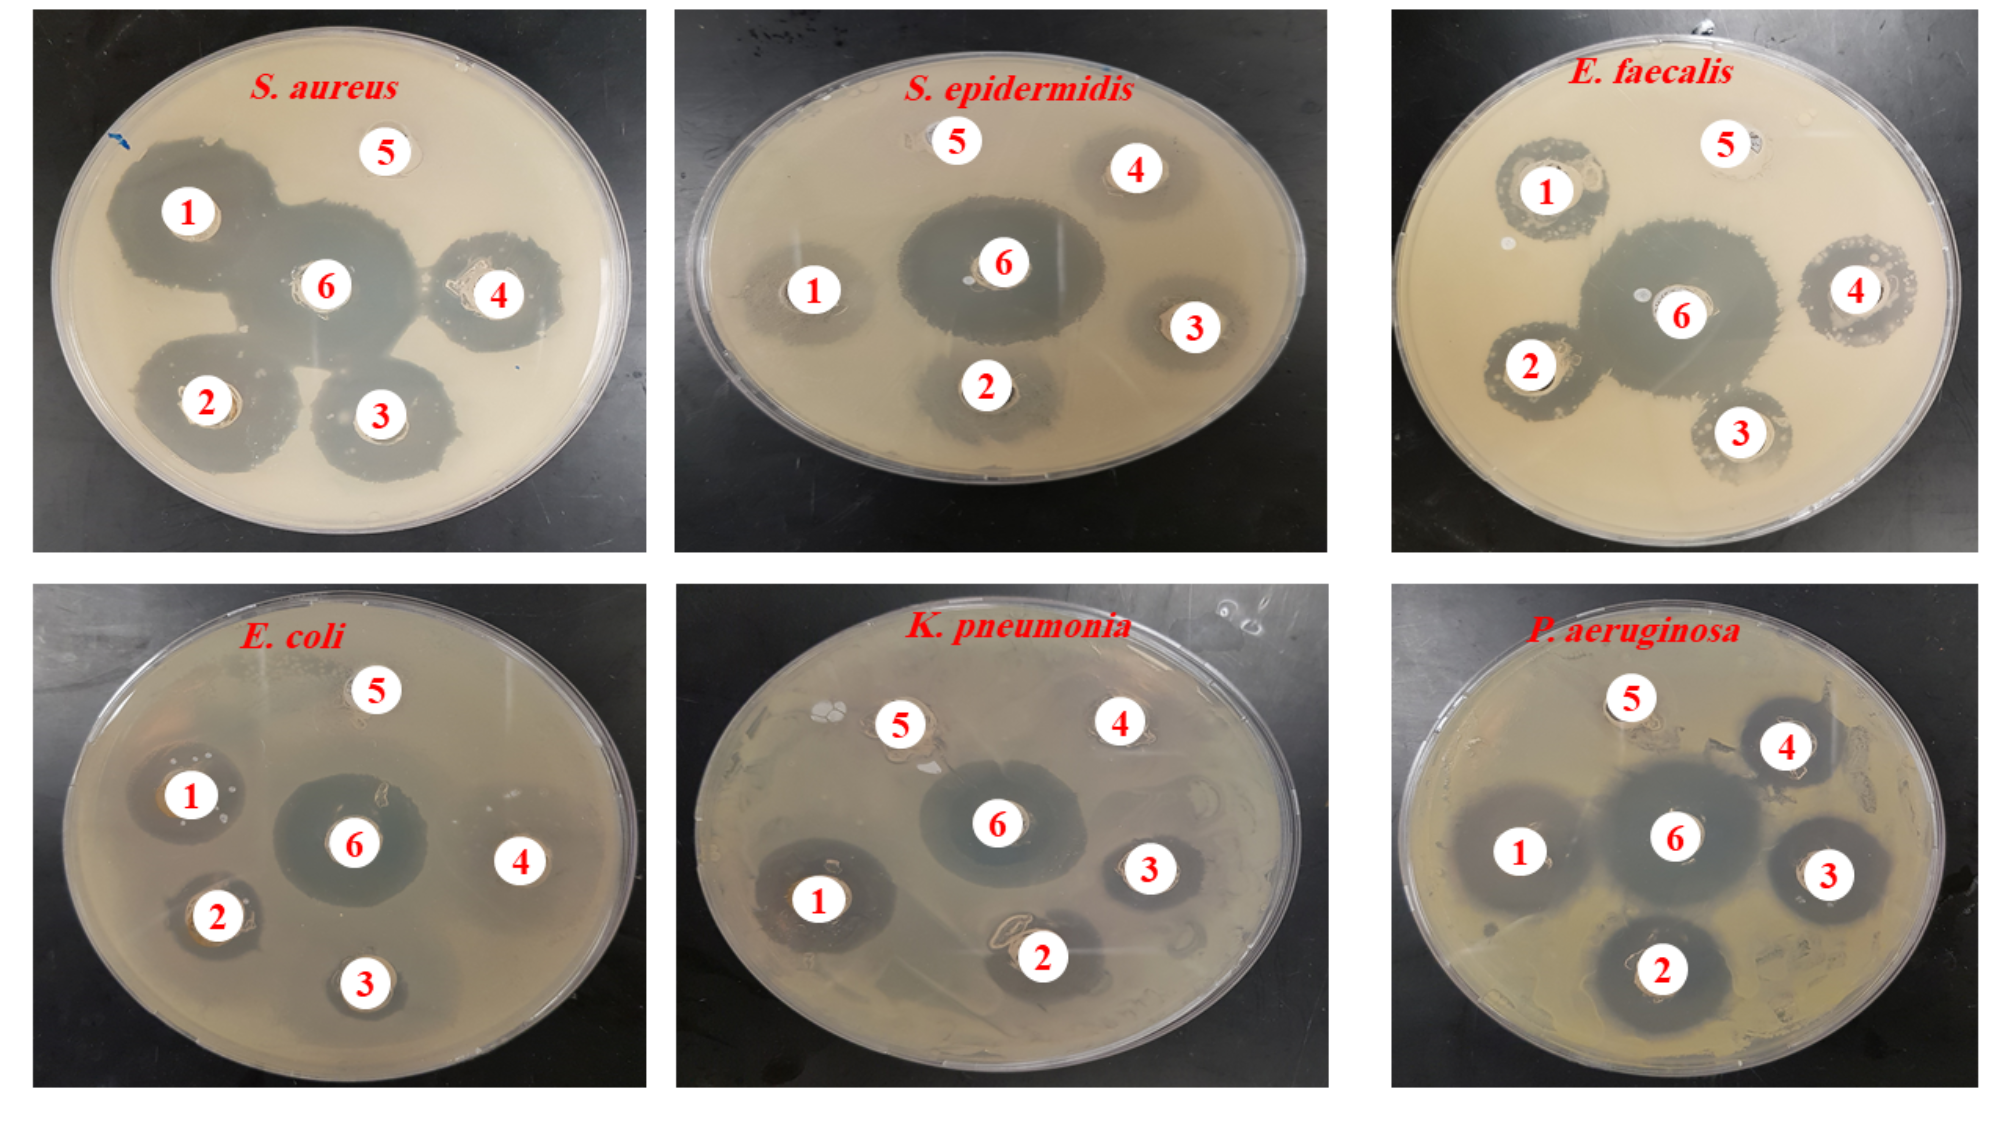
Fig. 11

Fig. 11
Antibiogram demonstrating the antibacterial activity of synthesized AgNPs against selected bacteria strains. (1) denotes 400 µg/ml; (2) denotes 200 µg/ml; (3) denotes 100 µg/ml; (4) denotes 50 µg/ml; (5) denotes the negative control; (6) denotes the ciprofloxacin (positive control).